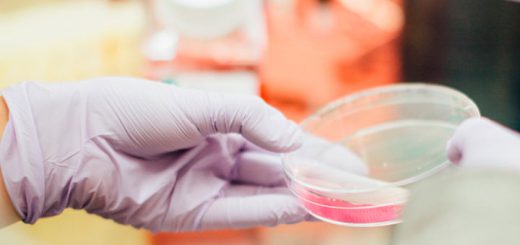

Santa Fe: presentaron el proyecto Ley del Árbol

Concluida la etapa de consulta y debate, será enviado a la Legislatura en los próximos días. Se suma al Plan Hídrico y al proyecto de preservación de bosques nativos, destacó el mandatario.
El gobernador Miguel Lifschitz presentó el proyecto definitivo de la denominada “ley del árbol”, que fue debatido por distintos actores de la sociedad académica y será enviado en los próximos días a la Legislatura provincial. El principal objetivo es defender e incrementar el arbolado en todo el territorio de Santa Fe.
“Este proyecto de ley persigue el objetivo de pensar el futuro de Santa Fe con crecimiento económico, valor agregado, generación de empleo y con cuidado y protección del medio ambiente y nuestros recursos naturales”, resumió el gobernador en la presentación que se realizó el viernes en Rosario.
“Está iniciativa tiene la mirada puesta en la Santa Fe del futuro, que se suma al Plan Hídrico presentado hace unos días y al proyecto de preservación de bosques nativos”, agregó.
Al hacer mención a la amplia participación de especialistas, el gobernador indicó: “No es habitual que los proyectos de ley tengan este nivel de participación, amplitud y pluralidad, lo que lo hace más valioso, porque no es una iniciativa del gobierno, sino una construcción colectiva”.
Por su parte, Claudia Alzugaray, docente de la Facultad de Ciencias Agrarias de Universidad Nacional de Rosario, también destacó la importancia de la ley: “Tenemos que cambiar la forma de producir, que es agresiva con el ambiente, el entorno, y las personas‘.
‘El árbol crea trabajo desde el momento que hay que ir a buscar la semilla, la cosecha, crea el plantín, lo ve crecer, lo cuida, lo planta y después puede decidir si lo quiere para madera o para flores”, expresó Alzugaray, y aseguró que “es esencial en un agrosistema ecológico y sustentable”.
El presidente del Colegio de Ingenieros Agrónomos, Gastón Huarte, convocó a establecer “áreas a forestar”, y destacó la “forma y la convocatoria para este proyecto de ley, en un ámbito plural, de búsqueda de consensos y aportes de distintos actores, que redundan en el enriquecimiento de la norma”.
Es una propuesta que busca recomponer un escenario transformado por un proceso extractivo, al que luego se sumó un proceso de cambio del uso de suelo. En ese marco, impulsa la creación de reservorios forestales de manera gradual y sostenida en todo el territorio provincial, tanto en el ámbito público como privado.
Para lograr esos objetivos, el anteproyecto declara al árbol de interés público y promueve la implantación de nuevos ejemplares, además de establecer y ampliar los corredores biológicos, crear un registro de árboles distinguidos y llevar a cabo un censo a nivel provincial de todo el material arbóreo.
También establece mínimos porcentajes a forestar por parte de los privados, entendiendo que los desafíos del calentamiento global deben ser asumidos por todos.
En ese marco, el Estado provincial toma un fuerte compromiso para el cumplimiento de la ley, creando el fondo santafesino de arbolado para solventar los requerimientos del sector público y privado.
La ley del árbol, una nueva política de Estado para las próximas generaciones, es producto de un trabajo coordinado entre los Ministerios de Medio Ambiente, de Producción, de Economía, y de Gobierno y Reforma del Estado, la Dirección Provincial de Vialidad y la Fiscalía de Estado. Además, se consideraron los proyectos legislativos ya presentados y se realizaron reuniones clave con colegios profesionales, entidades agrarias y universidades.
De la presentación, desarrollada en el Museo Ángel Gallardo de Rosario, participaron los ministros de Medio Ambiente, Jacinto Speranza; de la Producción, Luis Contigiani; de Innovación y Cultura, María de los Ángeles González; la intendente de Rosario, Mónica Fein; los senadores, Miguel Ángel Cappiello y Hugo Rasetto; y los diputados provinciales Clara García, Joaquín Blanco, Marita Ayala y Gabriel Real.
El objetivo del proyecto de ley es establecer una política de Estado en materia ambiental, a través de la promoción y la conservación del arbolado en todo el territorio provincial, generando un medio ambiente sano, equilibrado y apto para el desarrollo humano.
La norma declara actividad de interés público la promoción y conservación del arbolado y toda aquella que resulte conexa a la misma, para la generación de un medio ambiente sustentable. Prohíbe la extracción, poda y tala de ejemplares del arbolado público salvo excepciones, e insta a los municipios y comunas a elaborar un Plan de Gestión Integral del Arbolado Público.
Además, establece que los edificios públicos de propiedad del gobierno provincial contemplarán en su proyecto edilicio un índice mínimo de forestación, a la vez que se promoverá la concreción de corredores biológicos en los márgenes de rutas y caminos de jurisdicción provincial.
Por otra parte se establecen exigencias de arbolado en predios rurales del Estado provincial y en predios rurales privados.
Fuente: La Voz del Litoral